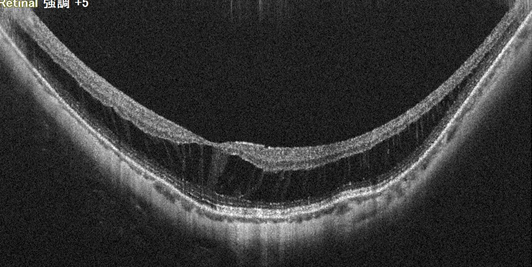
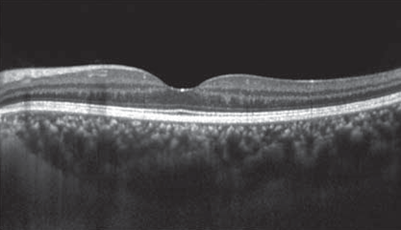

網脈絡膜萎縮
網脈絡膜萎縮
眼軸の伸展により、脈絡膜が菲薄化し、脈絡膜、網膜が障害されて萎縮する病態です。黄斑部に局在性萎縮が進行すると、視力が著しく低下します。


眼軸の伸展により、脈絡膜が菲薄化し、脈絡膜、網膜が障害されて萎縮する病態です。黄斑部に局在性萎縮が進行すると、視力が著しく低下します。

眼軸の伸展により、脈絡膜が菲薄化し、脈絡膜、網膜が障害されて萎縮する病態です。黄斑部に局在性萎縮が進行すると、視力が著しく低下します。
黄斑部の網膜が引き伸ばされて亀裂が生じ、本来血管のない黄斑部に、脈絡膜から新しい血管(脈絡膜新生血管)が伸びてくる病気です。新生血管はもろいため出血しやすく、出血すると視力低下やゆがみなどの症状が出ます。 病的近視の約10%に生じます。
網膜の血管の状態、出血や黄斑浮腫の状態を見ることができます。

蛍光色素の入った造影剤を腕の静脈から注射して、眼底カメラで眼底の血管を観察します。新生血管からの蛍光漏出が観察できます。

網膜の血管の状態、出血や黄斑浮腫の状態を見ることができます。

網膜は層構造になっており、その層構造を断面的に観察する検査です。
脈絡膜新生血管や浮腫の状態がわかります。